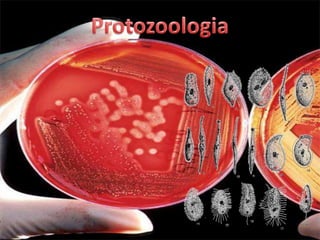
Protozoologia

Incrustar presentación
Descargado 20 veces















Este documento presenta una lista de diferentes ramas de la biología, incluyendo botánica, virología, bacteriología, protozoología, ficología, entomología, ornitología, herpetología, ictiología, mastozoología y malacología. El documento también menciona el nombre Edgar López Jiménez y su clase 3.A, así como los nombres de sus profesores de biología.